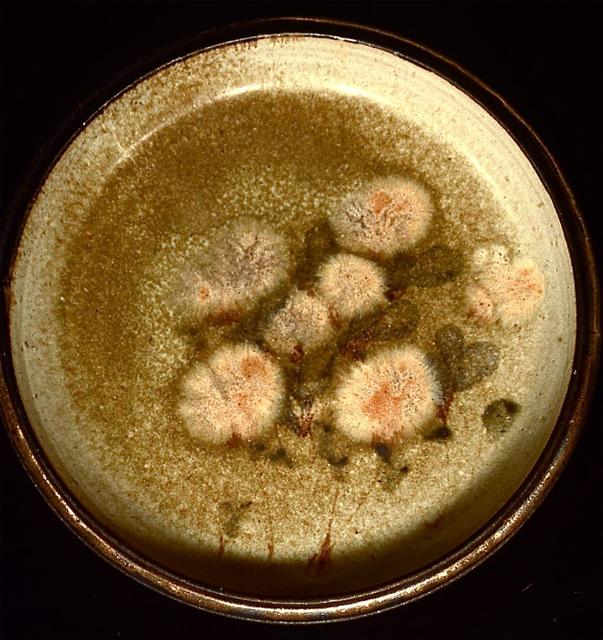

GALLERY
PLATES Back
I called this series 'Golden Summers.' It is a dinner plate.

This could properly called 'decoration.'

Another pot in the series 'Golden Summers.'
|
GALLERY PLATES Back |
I called this series 'Golden Summers.' It is a dinner plate.
This could properly called 'decoration.'
Another pot in the series 'Golden Summers.' |